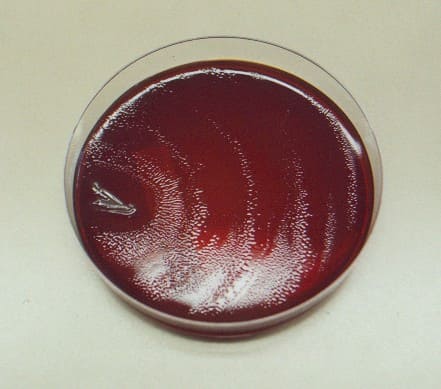
Протей на питательной среде

Инфекции, вызванные протеем, в настоящее время приобретают все большее распространение в силу совершенствования методов выявляемости, а также роста настороженности врачей к данной проблеме.
Протей – микроорганизм из группы условно-патогенных, относящийся к семейству Энтеробактерий (Еnterobacteriaceae), классу гамма-протеобактерии, типу протеобактерии (Proteobacteria). Основное место обитания протея – кишечник, в котором этот микроорганизм входит в состав нормальной микрофлоры. В норме в кале количество протея не должно превышать 104 КОЕ в 1 грамме испражнений. Протей – грамотрицательная (при окраске по Грамму не окрашивается) бактерия, является факультативным анаэробом (преимущественная жизнедеятельность в условиях отсутствия кислорода, однако и присутствие кислорода не является губительным), спор не образует. Протей – небольшой микроорганизм до 3 мкм, имеет вид нитей или нитевидных палочек, который отличаются высокой подвижностью. Протей обладают определенной биохимической активностью (например, выявлена их лецитиназная активность).
Выделяют несколько видов протея: Proteus mirabilis, Proteus vulgaris, Proteus myxofaciens, Proteus hauseri, Proteus penneri. Некоторые виды протея - P. morganii, P. rettgeri - отнесены к другим группам. Основные свойства патогенности протея – это способность вырабатывать эндотоксин (токсигенные свойства), а также гемолитические свойства. У протея, как и у многих представителей семейства Энтеробактерий, есть О-, Н-, К-антигены, по которым они подразделяются на серологические варианты, которых насчитывается около 110. Размножаются на специальных питательных средах (например, белковая питательная среда, мясопептонный агар, мясопептонный бульон, среда Плоскирева), оптимальная температура роста 370. Протей относительно устойчив во внешней среде, хорошо переносит замораживание, высокие температуры переносит хуже – при 600 погибает в течение 1 часа, при 800 – 5 минут. К дезинфицирующим растворам достаточно устойчив.
В микробиологии протей считается бактерией с санитарно-показательными свойствами. При обнаружении P. mirabilis делают вывод о степени фекального загрязнения исследуемого материала, а при обнаружении P. vulgaris – о степени загрязнения органическими веществами.

Причины возникновения инфекций, вызванных протеем
Не все виды протея являются патогенными для человека. К протеям, способным вызвать инфекцию, относятся P. mirabilis (до 85-90% всех заболеваний, вызванных протеем), P. vulgaris, P. penneri.
Источником инфекции для патогенных видов протея являются больной человек и животное, с испражнениями которых протей попадает во внешнюю среду (почва, водоемы, сточные воды, органические удобрения в стадии разложения), где может длительно сохранять жизнеспособность.
Механизм заражения – алиментарный, а пути водный (купание в сомнительных в плане их чистоты водоемах, заглатывание инфицированной воды) и пищевой (употребление в пищу мясных продуктов, молочных изделий, рыбы, колбасных продуктов, различных полуфабрикатов). Реже инфекция может передаваться контактно-бытовым путем (через загрязненные руки, загрязнение пупочной ранки новорожденных, заражение через урологические катетеры).
Группы риска для заражения протеем – это лица со сниженным иммунитетом либо возрастным (новорожденные и дети раннего возраста, пожилые люди), либо с сопутствующими хроническими заболеваниями кишечника, легких, органов брюшной полости. Также в группу риска входят лица, бесконтрольно принимающие антибактериальные препараты, то есть занимающиеся самолечением.
Симптомы и признаки инфекции, вызванной протеем
Инкубационный период (период с момента заражения до появления первых симптомов болезни) от нескольких часов (чаще 2-6 часов) до 3х дней.
1. Поражение желудочно-кишечного тракта – наиболее частое проявление протейной инфекции. Проявляется в виде гастроэнтерита, энтероколита, иногда гастрита. Как и при острых кишечных инфекциях начало может быть острым: появляются симптомы интоксикации – слабость и головные боли, снижение аппетита, иногда повышается температура до 37,5-39° в зависимости от тяжести процесса, при гастрите и гастроэнтерите частый симптом – это рвота, тошнота, почти сразу же появляются расстройства стула в виде водянистого стула с неприятным зловонным запахом, боли в животе непостоянные, чаще схваткообразного характера, больных беспокоит повышенное газообразование (метеоризм), «урчание» кишечника. Продолжительность болезни 4-5 дней.
Тяжелые формы протейной инфекции кишечника могут привести к развитию анемии, гемолитико-уремического синдрома, острой почечной недостаточности.
2. Дисбактериоз кишечника – регистрируется при превышении порога нормального содержания протей в испражнениях (более 104КОЕ/гр). Признаки дисбактериоза могут быть различными от небольшого послабления стула до водянистого стула после приема пищи до 2х раз за сутки.
3. Поражение мочевыводящих путей, вызванное протеем проявляется в виде пиелонефрита, цистита, простатита. Симптомы данных заболеваний не отличаются от них же, вызванных другой инфекцией.
4. Раневые инфекции, вызванные P. mirabilis. В группе риска по возникновению раневой инфекции – пациенты с трофическими язвами, пациенты ожоговых стационаров, пациенты травматологических отделений.
5. Внутрибольничные инфекции, вызванные протеем могут быть различными. Это и отиты, и холециститы, инфекции мочевыделительной системы, инфекции у новорожденных с развитием тяжелых форм в виде менингитов, сепсиса.
Диагностика протейных инфекций
Первичная диагностика происходит на основании выявления клинических симптомов конкретной формы инфекции, выявления групп риска для протейной инфекции, после которых требуется лабораторное подтверждение предварительного диагноза.
Лабораторная диагностика:
1) Бактериологический анализ испражнений и других материалов (моча, отделяемое ран, ожоговых поверхностей, гнойное отделяемое и другие). Посев производится на дифференциально-диагностические среды (Плоскирева), среды обогащения. При посеве протей растет в виде стелющегося тонкого налета в виде вуали голубоватого цвета. В испражнениях чаще выявляется P. vulgaris, присутствует приблизительно у 2% здоровых людей, но в небольшом количестве – до 104 КОЕ/гр. Превышение этого количества указывает на дисбактериоз кишечника, который чаще всего бывает ассоциированным (сочетанным) с обнаружением и других условно-патогенных бактерий (клебсиелла, цитробактер и другие).
При посеве мочи выявление протея называется бактериурия и указывает на поражение мочевыводящих путей. Истинная бактериурия (при отсутствии симптомов у больного) диагностируется при наличии протея в количестве не менее 105 микробных тел протея в 1 мл мочи (меньшее количество расценивается как загрязнение ее при заборе). Бактериурия (при наличии жалоб больного), а также при условии забора мочи из катетера диагностируется при выявлении 104 микробных тел протея в 1 мл мочи.
Протей на питательной среде
2) Серологические исследования – определение антител в крови (применяется редко, в основном для ретроспективной диагностики).
3) Вспомогательные исследования (общий анализ крови, мочи, биохимические исследования крови, копрограмма и другие) для выявления тяжести состояния больного.
Лечение инфекций, вызванных протеем
Организационно-режимные мероприятия сводятся к полупостельному и постельному режиму в зависимости от тяжести проявлений, соблюдение водного режима с целью восстановления потерь жидкости, щадящая диета с ограничением жирной и острой пищи.
Медикаментозное лечение инфекций, вызванных протеем
1) Специфические бактериофаги назначаются при избыточном росте протея. К рекомендуемым фагам относятся «Бактериофаг протейный жидкий», «Бактериофаг колипротейный жидкий», «Интести-бактериофаг жидкий», «Пиобактериофаг комбинированный жидкий», «Пиобактериофаг поливалентный очищенный жидкий». Бактерифаги назначаются за час-полтора до еды. Разовые дозировки рассчитаны в зависимости от возраста и составляют: до 6 мес – 10 мл, 6-12 мес – 10-15 мл, 1-3 года – 15-20 мл, 3-12 лет и старше 30 мл. Кратность приема и курс лечения определяет только лечащий врач. Перед приемом бактериофага необходимо попить щелочную минеральную воду.
2) Пробиотики и симбиотики для восстановления нормальной флоры кишечника (аципол, ацилакт, бифидумбактерин, бифиформ, линнекс, нормофлорин, биовестин, примадофилус и прочие). Назначаются натощак, курсом не менее 10-14 дней.
3) При выраженном росте протея у взрослых пациентов назначаются антибактериальные препараты (амоксицилин, нифуроксазид, цефалоспорины 3-4 поколений, фторхинолоны, стрептомицин). Перед назначением антибактериального препарата необходимо провести специальное исследование - антибиотикограмму материала для исключения ошибок лечения. К группе тетрациклинов некоторые штаммы протея устойчивы. Антибиотики назначаются только лечащим врачом!
4) Симптоматическое лечение – лечение конкретных симптомов болезни (жаропонижающие препараты, энтеросорбенты, обезболивающие, противовоспалительные, препараты, нормализующие водно-электролитный баланс и другие).
Профилактика протейных инфекций
1) Тщательное соблюдение санитарии в лечебно-профилактических учреждениях (особенно детского профиля).
2) Соблюдение гигиены в быту.
3) Употребление в пищу свежих и качественных продуктов, удаление из рациона питания подозрительных продуктов в плане качества.
4) Осторожность при купании в незнакомых водоемах, исключение заглатывания воды при купании.
5) Исключения контакта с больными детьми и взрослыми.
Врач инфекционист Быкова Н.И.




Комментарии
Лечение:пиобактериофаг на тощак 2 раза в день 10дн
нифуроксазид 2р/д
интерол
креон
интерожермина
Сдали повторно анализ то же самое
Чувствительность:Ампицилин+/-
Ципрофлоксацин+
Доксициклин-
Нитрофуратоин-
Амикацин+
Цефтриаксон+
Цефтазидим+
Цефотаксим+
Цефподоксим+/-
Цефокситин-
Прописали Цефодокс 3,5мл*2р*5дней
Лактиале 1пакетик на ночь 10 дн
Пожалуйста подскажите. Сейчас стул 1раз в день